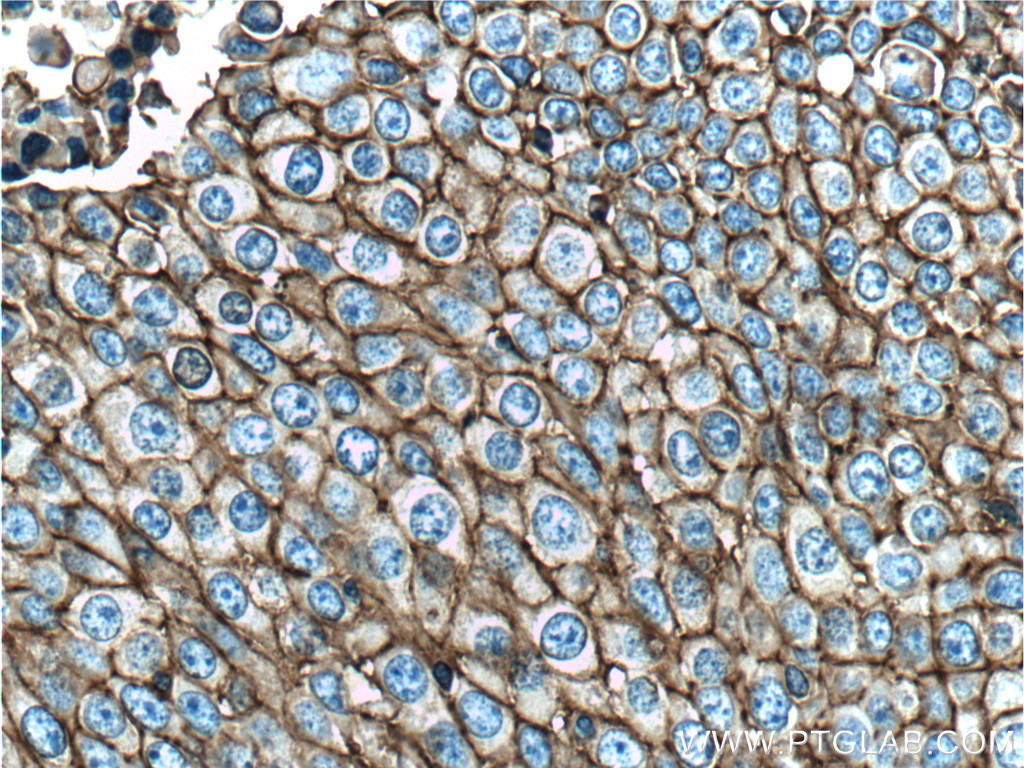
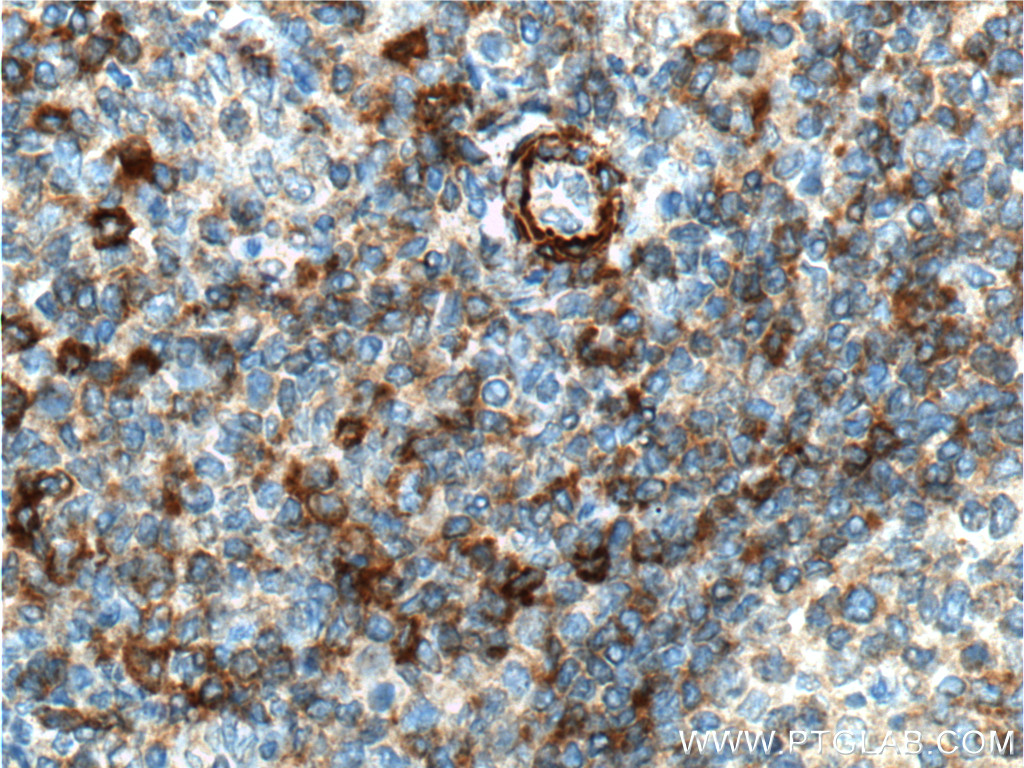

验证数据展示
经过测试的应用
| Positive WB detected in | MDA-MB-231 cells, human spleen tissue, HeLa cells, A549 cells, U-251 cells, HUVEC cells, pig spleen tissue |
| Positive IP detected in | HeLa cells |
| Positive IHC detected in | human lung cancer tissue, human breast cancer tissue, human oesophagus cancer tissue, human tonsillitis tissue Note: suggested antigen retrieval with TE buffer pH 9.0; (*) Alternatively, antigen retrieval may be performed with citrate buffer pH 6.0 |
| Positive IF-P detected in | human colon cancer tissue |
| Positive IF/ICC detected in | A431 cells |
推荐稀释比
| 应用 | 推荐稀释比 |
|---|---|
| Western Blot (WB) | WB : 1:5000-1:50000 |
| Immunoprecipitation (IP) | IP : 0.5-4.0 ug for 1.0-3.0 mg of total protein lysate |
| Immunohistochemistry (IHC) | IHC : 1:200-1:1000 |
| Immunofluorescence (IF)-P | IF-P : 1:200-1:800 |
| Immunofluorescence (IF)/ICC | IF/ICC : 1:400-1:1600 |
| It is recommended that this reagent should be titrated in each testing system to obtain optimal results. | |
| Sample-dependent, Check data in validation data gallery. | |
产品信息
60224-1-Ig targets CD44 in WB, IHC, IF/ICC, IF-P, IP, ELISA applications and shows reactivity with human, pig samples.
| 经测试应用 | WB, IHC, IF/ICC, IF-P, IP, ELISA Application Description |
| 文献引用应用 | WB, IHC, IF, IP, ELISA |
| 经测试反应性 | human, pig |
| 文献引用反应性 | human, rat, pig, rabbit |
| 免疫原 |
CatNo: Ag7633 Product name: Recombinant human CD44 protein Source: e coli.-derived, PET28a Tag: 6*His Domain: 28-380 aa of BC004372 Sequence: CRFAGVFHVEKNGRYSISRTEAADLCKAFNSTLPTMAQMEKALSIGFETCRYGFIEGHVVIPRIHPNSICAANNTGVYILTSNTSQYDTYCFNASAPPEEDCTSVTDLPNAFDGPITITIVNRDGTRYVQKGEYRTNPEDIYPSNPTDDDVSSGSSSERSSTSGGYIFYTFSTVHPIPDEDSPWITDSTDRIPATSTSSNTISAGWEPNEENEDERDRHLSFSGSGIDDDEDFISSTISTTPRAFDHTKQNQDWTQWNPSHSNPEVLLQTTTRMTDVDRNGTTAYEGNWNPEAHPPLIHHEHHEEEETPHSTSTIQATPSSTTEETATQKEQWFGNRWHEGYRQTPREDSHST 种属同源性预测 |
| 宿主/亚型 | Mouse / IgG2a |
| 抗体类别 | Monoclonal |
| 产品类型 | Antibody |
| 全称 | CD44 molecule (Indian blood group) |
| 别名 | 6F4H2, CD44 antigen, CDW44, CSPG8, ECMR III |
| 计算分子量 | 742 aa, 82 kDa |
| 观测分子量 | 80-95 kDa |
| GenBank蛋白编号 | BC004372 |
| 基因名称 | CD44 |
| Gene ID (NCBI) | 960 |
| ENSEMBL Gene ID | ENSG00000026508 |
| RRID | AB_11042767 |
| 偶联类型 | Unconjugated |
| 形式 | Liquid |
| 纯化方式 | Protein A purification |
| UNIPROT ID | P16070 |
| 储存缓冲液 | PBS with 0.02% sodium azide and 50% glycerol, pH 7.3. |
| 储存条件 | Store at -20°C. Stable for one year after shipment. Aliquoting is unnecessary for -20oC storage. |
背景介绍
CD44 is a type I transmembrane glycoprotein that mediates cell-cell and cell-matrix interactions through its affinity for hyaluronic acid (HA) and possibly also through its affinity for other ligands. Adhesion with HA plays an important role in cell migration, tumor growth and progression. CD44 is also involved in lymphocyte activation, recirculation and homing, and in hematopoiesis. This protein exists in multiple forms (with molecular weight ranging from 16 kDa to over 200 kDa) generated by alternative RNA splicing and extensive post-translational modifications.
实验方案
| Product Specific Protocols | |
|---|---|
| IF protocol for CD44 antibody 60224-1-Ig | Download protocol |
| IHC protocol for CD44 antibody 60224-1-Ig | Download protocol |
| IP protocol for CD44 antibody 60224-1-Ig | Download protocol |
| WB protocol for CD44 antibody 60224-1-Ig | Download protocol |
| Standard Protocols | |
|---|---|
| Click here to view our Standard Protocols |
发表文章
| Species | Application | Title |
|---|---|---|
Nat Methods Visualizing the native cellular organization by coupling cryofixation with expansion microscopy (Cryo-ExM). | ||
Clin Transl Med PADI4 facilitates stem-like properties and cisplatin resistance through upregulating PRMT2/IDs family in oesophageal squamous cell carcinoma | ||
Int J Biol Macromol A light-cured injectable composite hydrogel based on chitosan and decellularized matrix modulates stem cell aggregation behavior for accelerating cartilage defect repair | ||
Biomater Sci Magnetothermal heating facilitates the cryogenic recovery of stem cell-laden alginate-Fe(3)O(4) nanocomposite hydrogels | ||
Biomater Sci Vitrification of stem cell-laden core-shell microfibers with unusually low concentrations of cryoprotective agents |